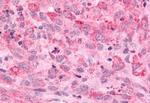
MINK1 Antibody in Immunohistochemistry (Paraffin) (IHC (P))

Search
Invitrogen
MINK1 Polyclonal Antibody
{{$productOrderCtrl.translations['antibody.pdp.commerceCard.promotion.promotions']}}
{{$productOrderCtrl.translations['antibody.pdp.commerceCard.promotion.viewpromo']}}
{{$productOrderCtrl.translations['antibody.pdp.commerceCard.promotion.promocode']}}: {{promo.promoCode}} {{promo.promoTitle}} {{promo.promoDescription}}. {{$productOrderCtrl.translations['antibody.pdp.commerceCard.promotion.learnmore']}}
产品信息
PA5-33936
种属反应
宿主/亚型
分类
类型
抗原
偶联物
形式
浓度
规格
纯化类型
保存液
内含物
保存条件
运输条件
RRID
产品详细信息
Percent identity with other species by BLAST analysis: Human, Gorilla, Monkey, Marmoset, Mouse, Rat, Elephant, Panda, Bovine, Bat, Horse, Pig (100%) Opossum (94%).
靶标信息
MINK1 is a serine/threonine kinase belonging to the germinal center kinase (GCK) family. The protein is structurally similar to the kinases that are related to NIK and may belong to a distinct subfamily of NIK-related kinases within the GCK family. Studies of the mouse homolog indicate an up-regulation of expression in the course of postnatal mouse cerebral development and activation of the cJun N-terminal kinase (JNK) and the p38 pathways.
仅用于科研。不用于诊断过程。未经明确授权不得转售。
篇参考文献 (0)
生物信息学
蛋白别名: FLJ18426; FLJ38123; FLJ94103; GCK family kinase; GCK family kinase MINK; hMINK; hMINKbeta; ISK; JLNS; JLNS2; LQT2/5; LQT5; MAPK/ERK kinase kinase kinase 6; MEK kinase kinase 6; MEKKK 6; MGC33114; Mink 1; Mink 2; mink1; Misshapen-like kinase 1; Misshapen/NIK-related kinase; Misshapen/NIKs-related kinase; Mitogen-activated protein kinase kinase kinase kinase 6; Yeast Sps1/Ste20-related kinase 2
基因别名: B55; MAP4K6; MEKKK 6; MINK; MINK1; YSK2; ZC3
UniProt ID: (Human) Q8N4C8, (Mouse) Q9JM52
Entrez Gene ID: (Bovine) 519558, (Horse) 100061370, (Human) 50488, (Pig) 100515409, (Mouse) 50932, (Rat) 303259